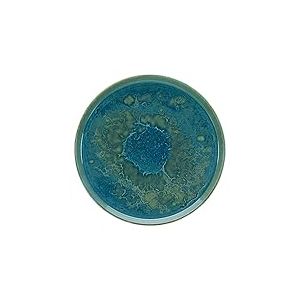
Creatable, 21508 S&eacute;rie Yuki Service de table 4 pi&egrave;ces en gr&egrave;s Passe au lave-vaisselle et au micro-ondes Fabriqu&eacute; au Portugal

| De | € | |
| à | € | ok |
Comparez ci-dessous les offres (non-exhaustives) fournies tous les jours par nos partenaires (référencés contre rémunération). Les résultats sont triés par défaut par popularité. C'est-à-dire que nous privilégions un produit par rapport à ses accessoires, et le nombre d'offres disponibles pour celui-ci.
Engagement Touslesprix.com : Aucune offre ne peut bénéficier d'un positionnement plus avantageux dans nos résultats de recherche en échange d'une rémunération.